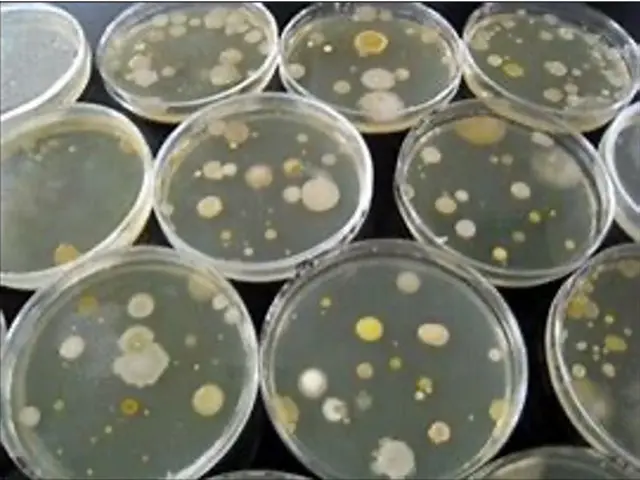
駐車料金無料！見た目より丁寧で安心しと感想を頂いています！お掃除機能は不可です。サービスの画像

採用情報はこちら

駐車料金無料!見た目より丁寧で安心しと感想を頂いています!お掃除機能は不可です。
電子決済可能です。
作業時間目安90分 / 台

店長:嘉手苅治
セールスポイント
paypay、auPAY、メルペイ・d払いがご利用出来ます。
当店を利用していただいたお客様だけに『臭いを抑える裏技』も教えちゃいます!
お掃除機能付きエアコンは申し訳ありませんが対応していません。
料金表
基本料金(税込)
| 1台 | ¥9,900 / 台 |
|---|---|
| 2台 | ¥8,000 / 台 |
| 3台 | ¥8,000 / 台 |
| 4台 | ¥8,000 / 台 |
| 5台以上 | ¥8,000 / 台 |
オプション料金(税込)
| 消臭抗菌コート | ¥2,000 / 台 |
|---|
口コミ
店舗の口コミ
4.90
(口コミ232件)
2025年5月・匿名さん
害虫駆除 / ゴキブリ駆除 / 居住住宅用
2025年10月・匿名さん
害虫駆除 / ゴキブリ駆除 / 居住住宅用
2025年8月・匿名さん
害虫駆除 / 蜂の巣駆除
2025年8月・匿名さん
害虫駆除 / 蜂の巣駆除
2025年7月・むうこさん
害虫駆除 / ゴキブリ駆除 / 居住住宅用
エアコンクリーニング / 壁掛けタイプの口コミ
4.88
(口コミ60件)
2023年4月・匿名さん
エアコンクリーニング / 壁掛けタイプ
2023年6月・匿名さん
エアコンクリーニング / 壁掛けタイプ
2023年6月・匿名さん
エアコンクリーニング / 壁掛けタイプ
2023年7月・匿名さん
エアコンクリーニング / 壁掛けタイプ
2023年5月・匿名さん
エアコンクリーニング / 壁掛けタイプ
作業内容
外装カバーの清掃 / フィルターの洗浄 / 本体内部の高圧洗浄 / ドレンパンの洗浄 / 作業場所の簡易清掃
- エアコンクリーニング / 壁掛けタイプのすべてのサービス共通の作業内容です。
作業までの流れ
このページにあるくらしのマーケットの予約ボタンをクリックして ネット予約をしてください。
予約確認
当社から予約確認の連絡をさせて頂きます。
作業
予約日時にお客様のところに伺い、作業いたします。
お支払い
予約時に選択された方法で作業料金をお支払いください。お支払い完了後は領収書などを受け取り、金額をご確認ください。
ご予約の前に
お客様へのお願い
・おそうじ機能付きエアコンは対応できません。必ず事前にお知らせください。
・カバーの洗い場としてお風呂またはベランダをお借りします。
・電気、水道をお借りします。
・エアコンの下は作業スペースになるため、荷物や家具がある場合は事前に移動をお願いします。
・高所に設置してあるエアコンの場合には、足場を作る必要があるため予約時にご連絡ください。
・取り外しができない、動作確認が出来ない、異音・故障しているなどのトラブルがある場合は、作業を承れないことがあります。
・専用の道具、洗剤を使用しますが、設備の劣化などにより塗装がはがれてしまう場合があります。
・変質や染色などの汚れは、クリーニングでは完全に落とすことができない場合があります。
・10年以上経過している機器については保障できない場合があります。
<ご予約に関する注意事項>
・直前でのご予約には対応できません。最低3日以上の余裕をもって、ご予約ください。
・ご予約の日時が、当社の営業時間内であることをご確認ください。
・予約の日程候補は、なるべく日時をずらしてください。
・予約が集中し、ご希望の日時に伺えない場合がございます。その場合は、[メッセージ]にて改めて日時をお伺いします。
よくある質問と答え
追加料金がかかる場合がありますか?
当日の急な追加料金は発生しません。必ず、お客様の状況を事前におしらせください。
無料で駐車できる場所がない場合はどうしたらいいですか?
付近の有料パーキングを使用しますが、その場合のパーキング代のご負担をお願いします。
キャンセルポリシー
キャンセル料金
| 作業日の5日前まで | ・・・ | 予約金額の0% |
|---|---|---|
| 作業日の2〜4日前 | ・・・ | 予約金額の25% |
| 作業日の前日 | ・・・ | 予約金額の50% |
| 作業日当日 | ・・・ | 予約金額の100% |
※作業日確定から48時間以内であれば、何日前でもキャンセル料は頂きません。
店舗について

店長:嘉手苅治
「抜苦与楽(ばっくよらく)」お客様の視点で丁寧な作業を心がけています。安心出来る作業でお客様の苦を抜き楽を与えます。
所在地
福岡県福岡市南区大池1-23-15
営業時間
定休日
対応エリア(出張費無料)
<九州・沖縄>
福岡県
- 福岡市東区
- 福岡市中央区
- 福岡市南区
- 福岡市西区
- 福岡市城南区
- 福岡市早良区
- 福岡市博多区
- 春日市
- 筑紫野市
- 古賀市
- 太宰府市
- 糟屋郡粕屋町
- 糟屋郡宇美町
- 糟屋郡久山町
- 糟屋郡志免町
- 糟屋郡篠栗町
- 糟屋郡新宮町
- 糟屋郡須惠町
- 大野城市
- 糸島市
この店舗のサービス

4.88
(20)
害虫駆除 / コバエ(チョウバエなど)駆除 / 居住住宅用
いや〜なコバエを駆除いたします。食品現場の駆除歴20年以上のスタッフが対応!
¥11,000

4.87
(81)
害虫駆除 / ゴキブリ駆除 / 居住住宅用
《選べる再施工保証期間!》駆除歴20年以上の経験と保証でお客様から高評価です。
¥13,200

4.96
(66)
害虫駆除 / 蜂の巣駆除
【アシナガ11,000円、スズメバチ16,500円(基本)】アフターフォロ―対応
¥16,500

4.84
(3)
レンジフード(換気扇)クリーニング / レンジフードタイプ
安心の油汚れ専用洗剤を使用しています。追加料金はありません。顔写真は少し古いです
¥12,100